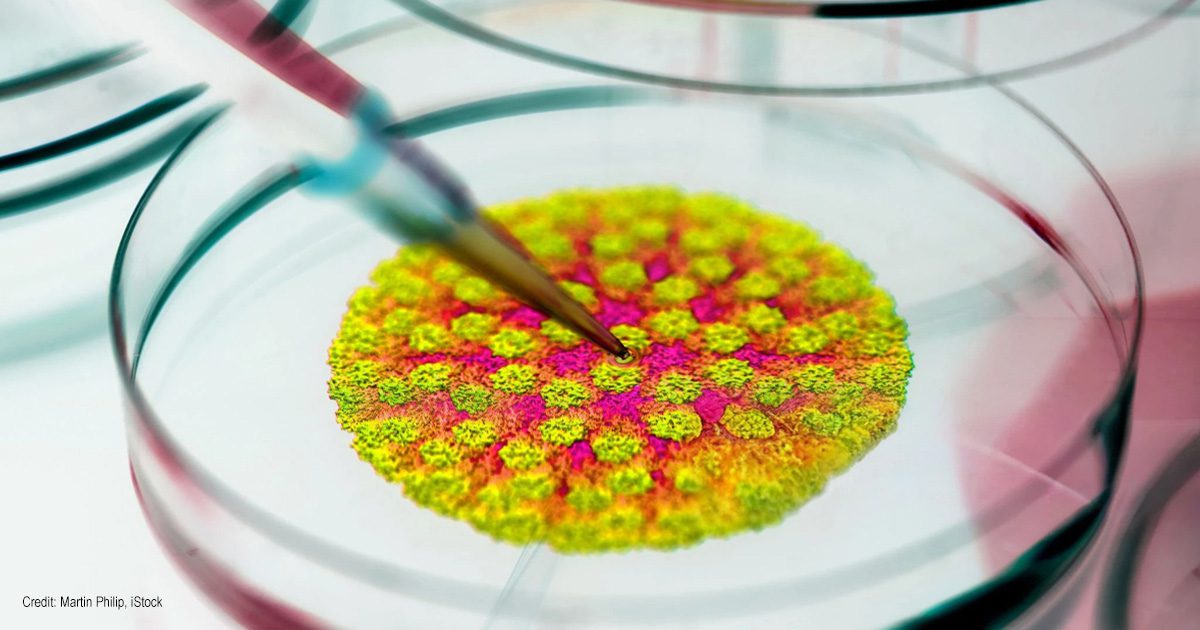
Tox Lab | Credit: Martin Philip, iStock

May 29, 2025 The Jingles Awards: The Power of Anecdotes
Around 1990, the Delta Society (now Pet Partners – an organization supporting animal-assisted activities and therapy) held its annual meeting in New Jersey. During one of the lunchtime sessions, five Jingles Awards were issued to five human-animal teams representing different areas of human-animal cooperation. The...